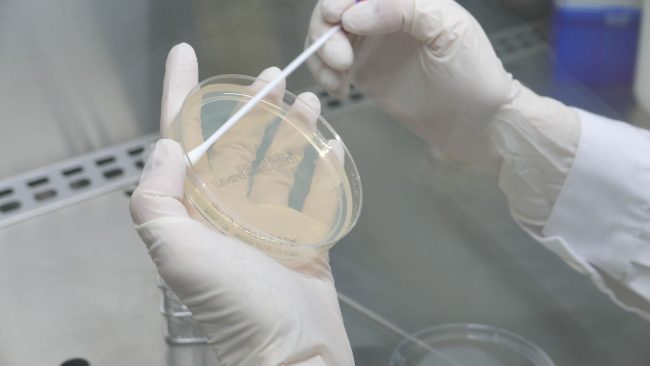
1721726233059

Antibiogramas
Realizar antibiogramas es una tarea diaria para nosotras y fundamental para el sector animal. Procesamos las muestras recibidas y mediante esta técnica determinamos la susceptibilidad bacteriana y los antibióticos más efectivos para tratar cada caso. Durante todo el proceso, seguimos estrictos protocolos de calidad y seguridad para garantizar la precisión de los resultados. Desde Zenit…